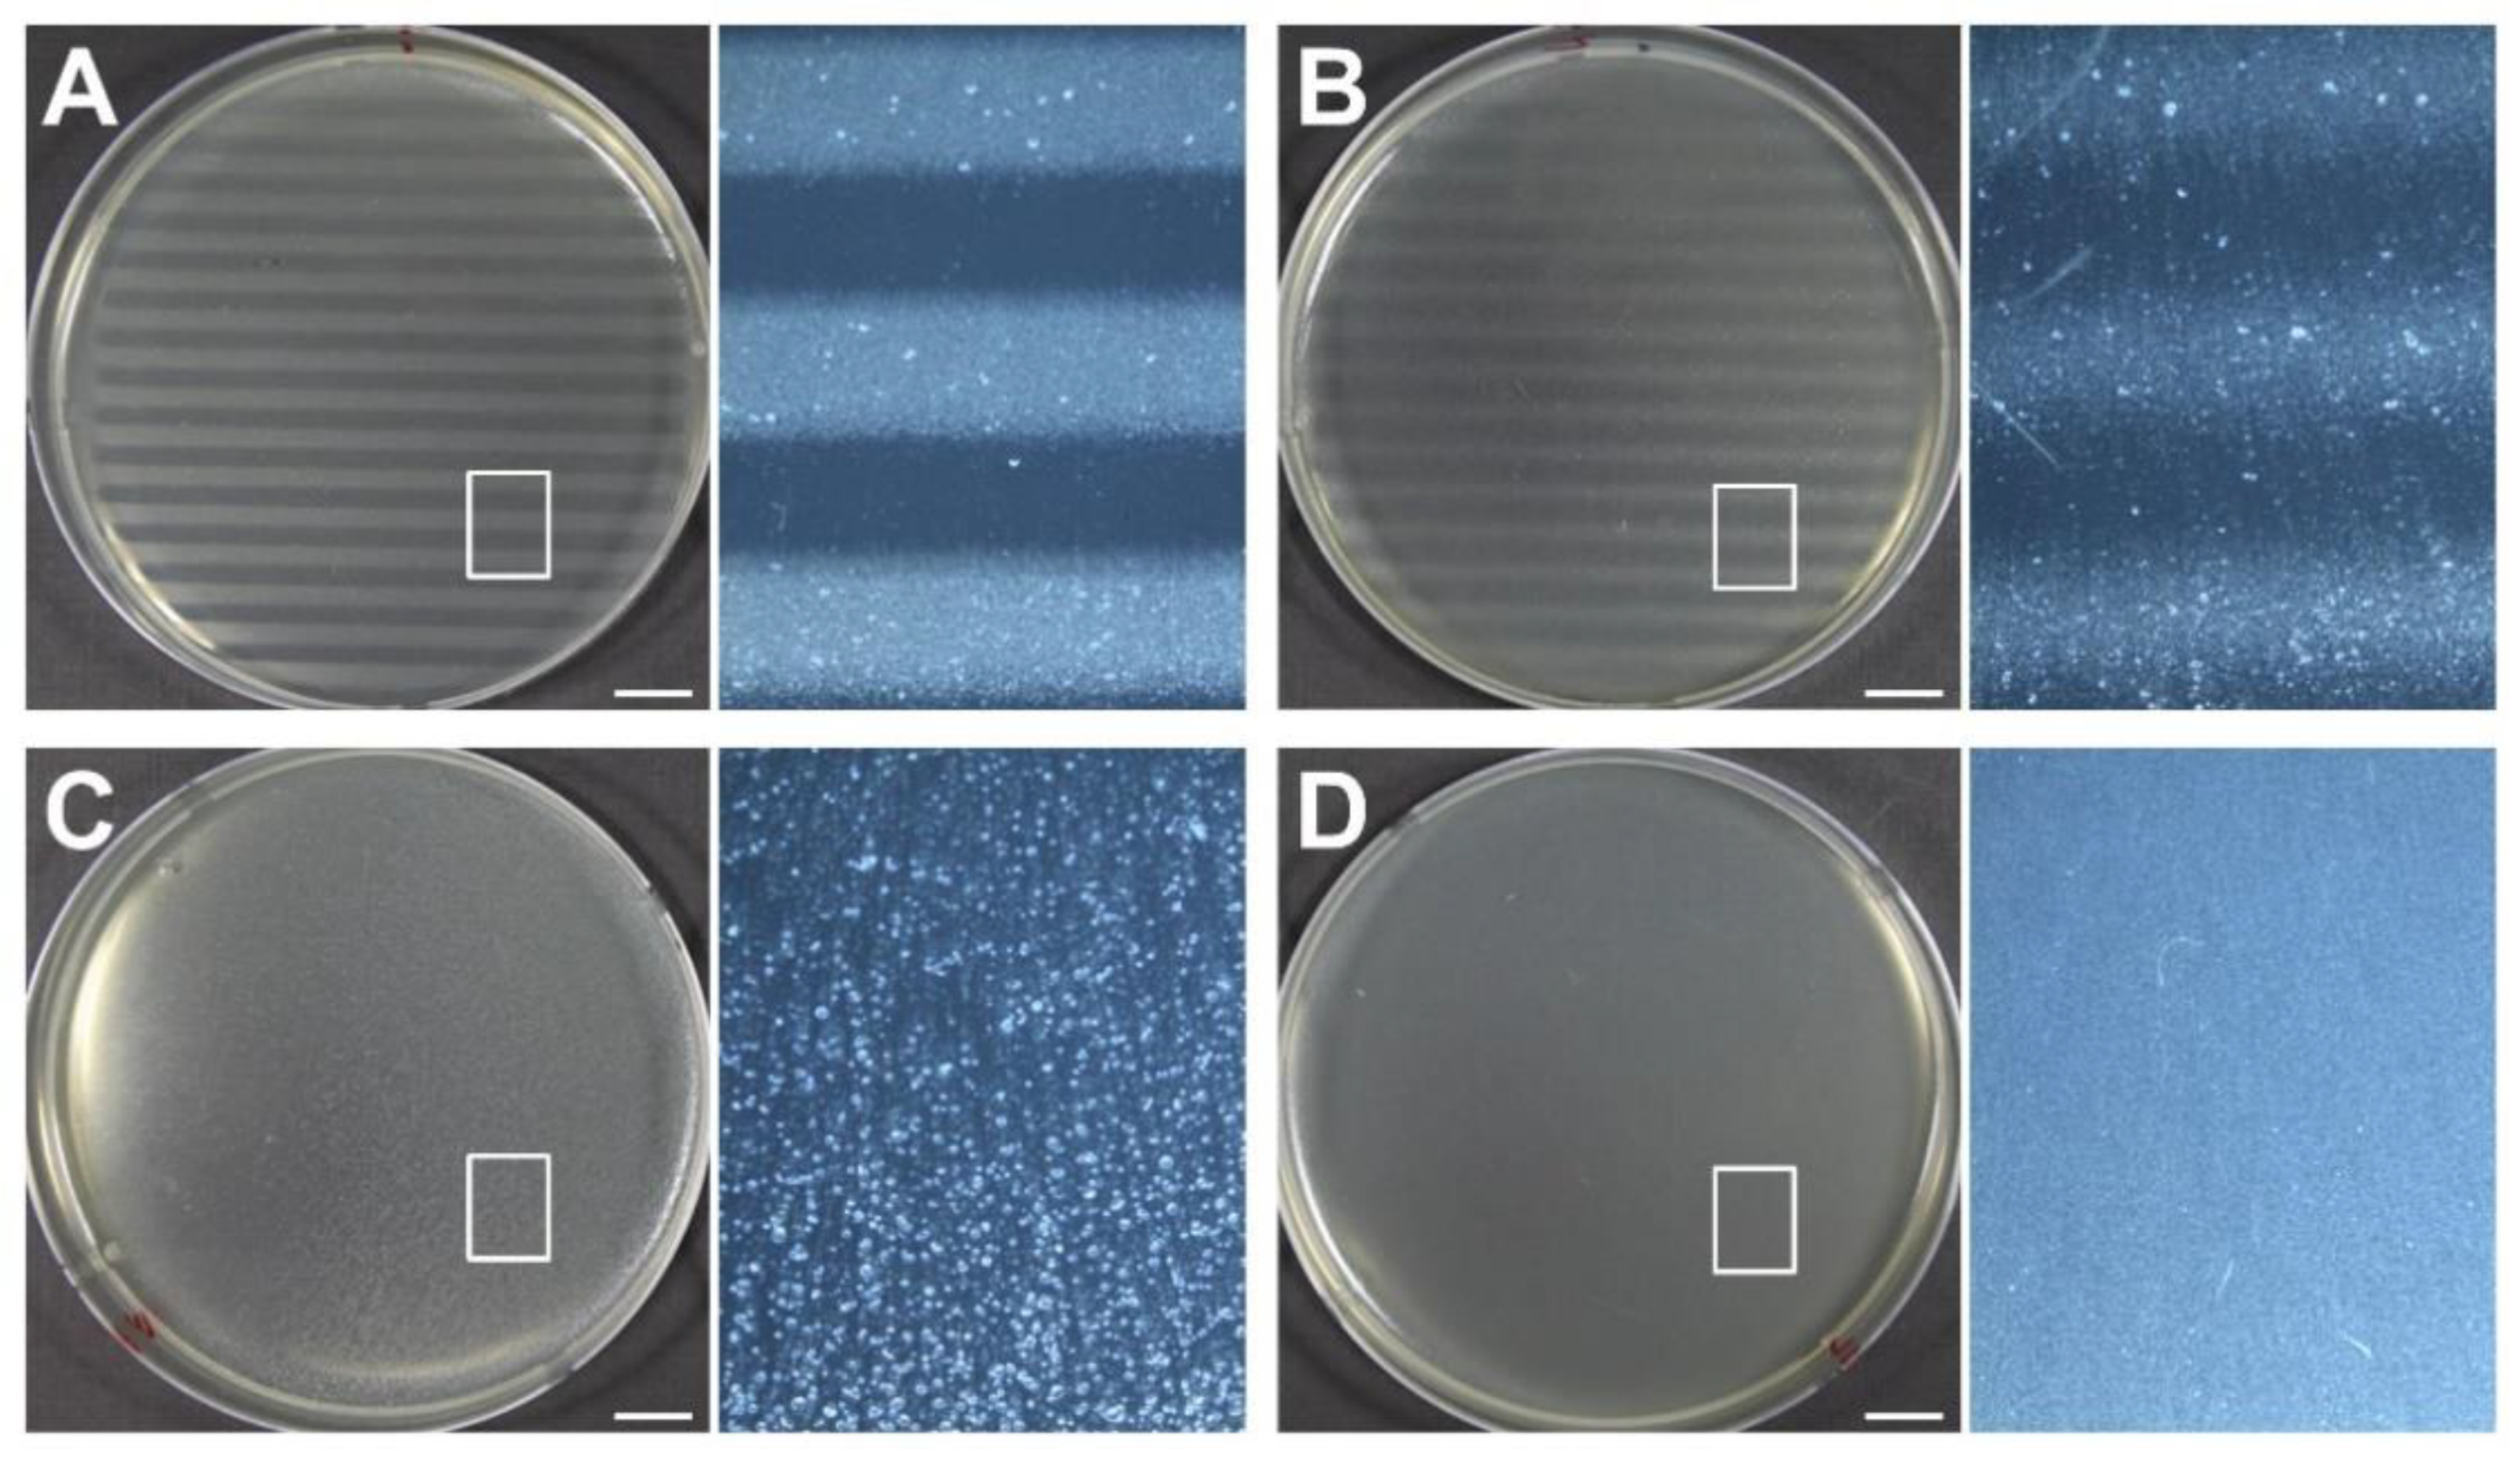
Cancers 14 02888 g007 Cancers 14 02888 g007

Dose Profile Modulation of Proton Minibeam for Clinical Application
Abstract
Simple Summary
Abstract
1. Introduction
2. Materials and Methods
2.1. Monte Carlo Simulation
2.2. Fabrication of Components for pMBRT
2.3. Measurement of Lateral Dose Profiles
2.4. Biological Response to Proton Minibeams
3. Results
3.1. Monte Carlo Simulation
3.1.1. Validation of MC Simulation
3.1.2. Effect of a Diverging Slit on the Lateral Dose Profiles
3.1.3. Effect of MSC Thickness on PVDR
3.1.4. Effect of the Scatterer on PVDR
3.2. Measurement of Lateral and Longitudinal Dose Profiles
3.3. Biological Response to Proton Minibeams
4. Discussion
5. Conclusions
Supplementary Materials
Author Contributions
Funding
Institutional Review Board Statement
Informed Consent Statement
Data Availability Statement
Acknowledgments
Conflicts of Interest
References
- Wilson, R.R. Radiological use of fast protons. Radiology 1946, 47, 487–491. [Google Scholar] [CrossRef] [PubMed]
- Brown, A.; Suit, H. The centenary of the discovery of the Bragg peak. Radiother. Oncol. 2004, 73, 265–268. [Google Scholar] [CrossRef]
- Prezado, Y.; Fois, G.R. Proton-minibeam radiation therapy: A proof of concept. Med. Phys. 2013, 40, 31712. [Google Scholar] [CrossRef] [PubMed]
- Zlobinskaya, O.; Girst, S.; Greubel, C.; Hable, V.; Siebenwirth, C.; Walsh, D.W.; Multhoff, G.; Wilkens, J.J.; Schmid, T.E.; Dollinger, G. Reduced side effects by proton microchannel radiotherapy: Study in a human skin model. Radiat. Environ. Biophys. 2013, 52, 123–133. [Google Scholar] [CrossRef] [PubMed]
- Girst, S.; Greubel, C.; Reindl, J.; Siebenwirth, C.; Zlobinskaya, O.; Walsh, D.W.M.; Ilicic, K.; Aichler, M.; Walch, A.; Wilkens, J.J.; et al. Proton minibeam radiation therapy reduces side effects in an in vivo mouse ear model. Int. J. Radiat. Oncol. Biol. Phys. 2016, 95, 234–241. [Google Scholar] [CrossRef] [PubMed]
- Lee, E.; Meyer, J.; Sandison, G. Collimator design for spatially-fractionated proton beams for radiobiology research. Phys. Med. Biol. 2016, 61, 5378–5389. [Google Scholar] [CrossRef]
- Prezado, Y.; Jouvion, G.; Hardy, D.; Patriarca, A.; Nauraye, C.; Bergs, J.; González, W.; Guardiola, C.; Juchaux, M.; Labiod, D.; et al. Proton minibeam radiation therapy spares normal rat brain: Long-term clinical, radiological and histopathological analysis. Sci. Rep. 2017, 7, 14403. [Google Scholar] [CrossRef]
- Marzi, L.; Patriarca, A.; Nauraye, C.; Hierso, E.; Dendale, R.; Guardiola, C.; Prezade, Y. Implementation of planar proton minibeam radiation therapy using a pencil beam scanning system: A proof of concept study. Med. Phys. 2018, 45, 5305–5316. [Google Scholar] [CrossRef]
- Sammer, M.; Zahnbrecher, E.; Dobiasch, S.; Girst, S.; Greubel, C.; Ilicic, K.; Reindl, J.; Schwarz, B.; Siebenwirth, C.; Walsh, D.W.M.; et al. Proton pencil minibeam irradiation of an in-vivo mouse ear model spares healthy tissue dependent on beam size. PLoS ONE 2019, 14, e0224873. [Google Scholar] [CrossRef]
- Lansonneur, P.; Mammar, H.; Nauraye, C.; Patriarca, A.; Hierso, E.; Dendale, R.; Prezado, Y.; De Marzi, L. First proton minibeam radiation therapy treatment plan evaluation. Sci. Rep. 2020, 10, 7025. [Google Scholar] [CrossRef]
- Curtis, H.J. The use of deuteron microbeam for simulating the biological effects of heavy cosmic-ray particles. Radiat. Res. Suppl. 1967, 7, 250–257. [Google Scholar] [CrossRef] [PubMed]
- Hopewell, J.W.; Trott, K.R. Volume effects in radiobiology as applied to radiotherapy. Radiother. Oncol. 2000, 56, 283–288. [Google Scholar] [CrossRef]
- Crosbie, J.C.; Anderson, R.L.; Rothkamm, K.; Restall, C.M.; Cann, L.; Ruwanpura, S.; Meachem, S.; Yagi, N.; Svalbe, I.; Lewis, R.A.; et al. Tumor cell response to synchrotron microbeam radiation therapy differs markedly from cells in normal tissues. Int. J. Radiat. Oncol. Biol. Phys. 2010, 77, 886–894. [Google Scholar] [CrossRef]
- Serduc, R.; Vérant, P.; Vial, J.C.; Farion, R.; Rocas, L.; Rémy, C.; Fadlallah, T.; Brauer, E.; Bravin, A.; Laissue, J.; et al. In Vivo two-photon microscopy study of short-term effects of microbeam irradiation on normal mouse brain microvasculature. Int. J. Radiat. Oncol. Biol. Phys. 2006, 64, 1519–1527. [Google Scholar] [CrossRef] [PubMed]
- Dilmanian, F.A.; Qu, Y.; Feinendegen, L.E.; Peña, L.A.; Bacarian, T.; Henn, F.A.; Kalef-Ezra, J.; Liu, S.; Zhong, Z.; McDonald, J.W. Tissue-sparing effect of X-ray microplanar beams particularly in the CNS: Is a bystander effect involved? Exp. Hematol. 2007, 35, 69–77. [Google Scholar] [CrossRef] [PubMed]
- Bouchet, A.; Serduc, R.; Laissue, J.A.; Djonov, V. Effects of microbeam radiation therapy on normal and tumoral blood vessels. Phys. Med. 2015, 31, 634–641. [Google Scholar] [CrossRef] [PubMed]
- Sammer, M.; Dombrowsky, A.C.; Schauer, J.; Oleksenko, K.; Bicher, S.; Schwarz, B.; Rudigkeit, S.; Matejka, N.; Reindl, J.; Bartzsch, S.; et al. Normal tissue response of combined temporal and spatial fractionation in proton minibeam radiation therapy. Int. J. Radiat. Oncol. Biol. Phys. 2021, 109, 76–83. [Google Scholar] [CrossRef]
- Dilmanian, F.A.; Eley, J.G.; Krishnan, S. Minibeam therapy with protons and light ions: Physical feasibility and potential to reduce radiation side effects and to facilitate hypofractionation. Int. J. Radiat. Oncol. Biol. Phys. 2015, 92, 469–474. [Google Scholar] [CrossRef]
- McAuley, G.; Lim, C.; Teran, A.; Slater, J.; Wroe, A. Monte Carlo evaluation of high-gradient magnetically focused planar proton minibeam in a passive nozzle. Phys. Med. Biol 2022, 67, 115006. [Google Scholar] [CrossRef]
- Mayerhofer, M.; Datzmann, G.; Degiovanni, A.; Dimov, V.; Dollinger, G. Magnetically focused 70 MeV proton minibeams for preclinical experiments combining a tandem accelerator and a 3 GHz linear post-accelerator. Med. Phys. 2021, 48, 2733–2749. [Google Scholar] [CrossRef]
- Schneider, T.; De Marzi, L.; Patriarca, A.; Prezado, Y. Advancing proton minibeam radiation therapy: Magnetically focussed proton minibeams at a clinical centre. Sci. Rep. 2020, 10, 1384. [Google Scholar] [CrossRef] [PubMed]
- Cavallone, M.; Prezado, Y.; Marzi, L. Converging proton minibeams with magnetic fields for optimized radiation therapy: A proof of concept. Cancers 2021, 14, 26. [Google Scholar] [CrossRef] [PubMed]
- Sotiropoulos, M.; Prezado, Y. A scanning dynamic collimator for spot–Scanning proton minibeam production. Sci. Rep. 2021, 11, 18321. [Google Scholar] [CrossRef] [PubMed]
- Zhao, L.; Das, I. Gafchromic EBT film dosimetry in proton beams. Phys. Med. Biol. 2010, 55, N291–N301. [Google Scholar] [CrossRef]
- Sammer, M.; Teiluf, K.; Girst, S.; Greubel, C.; Reindl, J.; Ilicic, K.; Walsh, D.W.M.; Aichler, M.; Walch, A.; Combs, S.E.; et al. Beam size limit for pencil minibeam radiotherapy determined from side effects in an in-vivo mouse ear model. PLoS ONE 2019, 14, e0221454. [Google Scholar] [CrossRef]
- Bues, M.; Newhauser, W.D.; Titt, U.; Smith, A.R. Therapeutic step and shoot proton beam spot-scanning with a multi-leaf collimator: A Monte Carlo study. Radiat. Prot. Dosim. 2005, 115, 164–169. [Google Scholar] [CrossRef]
- Howell, R.M.; Burgett, E.A.; Isaacs, D.; Hedrick, S.G.P.; Reilly, M.P.; Rankine, L.J.; Grantham, K.K.; Perkins, S.; Klein, E.E. Measured neutron spectra and dose equivalents from a Mevion single-room, passively scattered proton system used for craniospinal irradiation. Int. J. Radiat. Oncol. Biol. Phys. 2016, 95, 249–257. [Google Scholar] [CrossRef][Green Version]
- Guardiola, C.; Peucelle, C.; Prezado, Y. Optimization of the mechanical collimation for minibeam generation in proton minibeam radiation therapy. Med. Phys. 2017, 44, 1470–1478. [Google Scholar] [CrossRef]
- Coutrakon, G.; Slater, J.M.; Ghebremedhin, A. Design considerations for medical proton accelerators. In Proceedings of the Particle Accelerator Conference, New York, NY, USA, 27 March–2 April 1999. [Google Scholar]
- Pidikiti, R.; Patel, B.C.; Maynard, M.R.; Dugas, J.P.; Syh, J.; Sahoo, N.; Wu, H.T.; Rosen, L.R. Commissioning of the world’s first compact pencil-beam scanning proton therapy system. J. Appl. Clin. Med. Phys. 2018, 19, 94–105. [Google Scholar] [CrossRef]

Publisher’s Note: MDPI stays neutral with regard to jurisdictional claims in published maps and institutional affiliations. |
© 2022 by the authors. Licensee MDPI, Basel, Switzerland. This article is an open access article distributed under the terms and conditions of the Creative Commons Attribution (CC BY) license (https://creativecommons.org/licenses/by/4.0/).
Share and Cite
Kim, M.; Hwang, U.-J.; Park, K.; Kim, D.; Kim, H.S.; Choi, S.H.; Jeong, J.H.; Shin, D.; Lee, S.B.; Kim, J.-Y.; et al. Dose Profile Modulation of Proton Minibeam for Clinical Application. Cancers 2022, 14, 2888. https://doi.org/10.3390/cancers14122888
Kim M, Hwang U-J, Park K, Kim D, Kim HS, Choi SH, Jeong JH, Shin D, Lee SB, Kim J-Y, et al. Dose Profile Modulation of Proton Minibeam for Clinical Application. Cancers. 2022; 14(12):2888. https://doi.org/10.3390/cancers14122888
Chicago/Turabian StyleKim, Myeongsoo, Ui-Jung Hwang, Kyeongyun Park, Dohyeon Kim, Hak Soo Kim, Sang Hyoun Choi, Jong Hwi Jeong, Dongho Shin, Se Byeong Lee, Joo-Young Kim, and et al. 2022. "Dose Profile Modulation of Proton Minibeam for Clinical Application" Cancers 14, no. 12: 2888. https://doi.org/10.3390/cancers14122888
APA StyleKim, M., Hwang, U.-J., Park, K., Kim, D., Kim, H. S., Choi, S. H., Jeong, J. H., Shin, D., Lee, S. B., Kim, J.-Y., Kim, T. H., Baek, H. J., Kim, H., Kim, K., Kim, S. S., & Lim, Y. K. (2022). Dose Profile Modulation of Proton Minibeam for Clinical Application. Cancers, 14(12), 2888. https://doi.org/10.3390/cancers14122888

